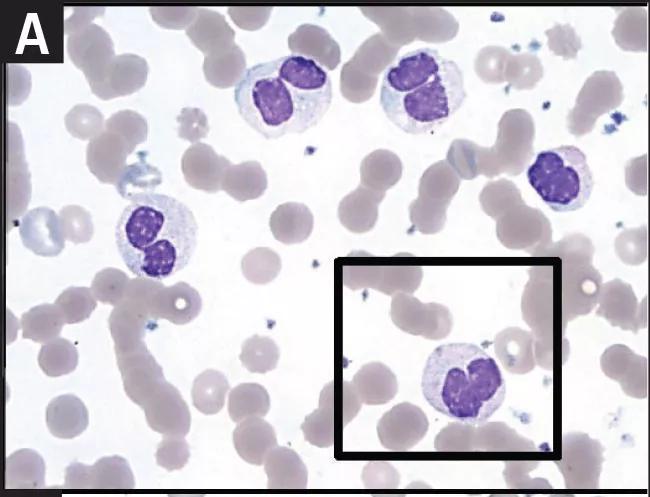

Complex cases requiring multidisciplinary care
Image content: This image is available to view online.
View image online (https://assets.clevelandclinic.org/transform/890698dd-bc57-4c51-bd99-4b134e316e71/16-PUL-2260-Fernandez-Inset-Image-02-650pxl-width-1_jpg)
16-pul-2260-fernandez-inset-image-02-650pxl-width
By James Fernandez, MD, PhD, Leonard Calabrese, DO, and Maria Barcena Blanch, MD
Advertisement
Cleveland Clinic is a non-profit academic medical center. Advertising on our site helps support our mission. We do not endorse non-Cleveland Clinic products or services. Policy
A 57-year-old man with history of COPD, coronary artery disease (CAD), and atrial fibrillation required admission to the hospital due to worsening cardiac symptoms associated with CAD and aortic insufficiency.
Throughout his teenage years and early 30s, he had necrotic skin ulcerations involving his upper and lower extremities that required two- to four-week courses of parenteral antibiotic therapy four to five times per year. His symptoms subsided by the age of 40, with spontaneous resolution of his recurrent skin lesions. He had no further history of recurrent infections involving skin or other systems after the age of 40. However, he developed a severe postoperative infection after a coronary artery bypass graft (CABG) and aortic valve repair performed at age 53, resulting in mediastinitis requiring surgical intervention, skin flap and prolonged IV antibiotic course.
During the current admission, aortic valve replacement and redo CABG were recommended by the cardiac surgical team. Due to this history of postoperative infection and poor wound healing, he was deemed a high-risk surgical candidate and required preoperative evaluation by immunology and infectious disease.
The physical exam was fairly unremarkable. His labs revealed a WBC of 8.36 x 103/uL, hemoglobin of 10.7 g/dL, hematocrit 33.6 percent, MCV 88 fL, platelets 462 x 103/uL, total protein 6.8 g/dL, with normal liver and renal function tests. Immunologic and infectious workup showed IgE 16.7 mg/dL, IgA 483 mg/dL, IgG 1020 mg/dL, IgM 69 mg/dL, protective titers against tetanus and pneumococcal serotypes, normal LTT mitogen, syphilis IgG negative, nonreactive HIV, and negative hepatitis screen and fungal battery. He underwent redo open heart surgery consisting of aortic valve replacement and CABG without intraoperative complications.
Advertisement
His postoperative course was complicated by leukocytosis (WBC 27.6 x 103/uL; neutrophils 87 percent, lymphocytes 6.8 percent, monocytes 1.4 percent) and increased ESR (39), wound dehiscence, sternal wound osteomyelitis and development of enterococcal bacteremia. He required treatment with wound vac placement and prolonged IV vancomycin.

Image content: This image is available to view online.
View image online (https://assets.clevelandclinic.org/transform/5bbb6317-3920-459d-bdcb-85203aa257d8/16-PUL-2260-Fernandez-Inset-Image-02-650pxl-width_jpg)
A: Peripheral blood smear showing hyposegmented neutrophils, particularly bilobed neutrophils with significantly reduced cytoplasmic granulation; representative cell is highlighted in box (Wright-Giemsa stain x1000). B: Myeloperoxidase stain shows reduced myeloperoxidase reaction in patient’s neutrophils. Normal reaction pattern from healthy donor is shown in insert (images x1000).
Peripheral blood smear showed leukocytosis with neutrophilia with mature segmented neutrophils. Interestingly, the majority of neutrophils showed hyposegmentation, particularly bilobed nucleus similar to Pelger-Huet anomaly, and occasionally small, fragmented nuclei (microlobes) were present. All neutrophils demonstrated pale cytoplasm because of significant decrease in cytoplasmic granulation. Myeloperoxidase stain showed mild myeloperoxidase reaction in neutrophils; however, it was significantly reduced compared with the reactions in normal neutrophils from a healthy donor. Although only a few eosinophils were present in the peripheral blood smears, cytoplasmic granules appeared decreased. No other inclusions in the granulocytes or immature granulocytes were noted.
The below figure shows the ultrastructure of granulocytes by electron microscopy, demonstrating mature, segmented neutrophils with many bilobed forms and occasional microlobes. Segmented neutrophils had abundant cytoplasm, rich glycogen particles and Golgi zone. Primary (azurophilic) and tertiary granules were present, but decreased in the neutrophils. Secondary (specific) granules were markedly decreased or absent in the neutrophils examined.
Advertisement
A: Ultrastructure of neutrophils shows predominantly bilobed neutrophils with occasional microlobes (x4,800). B-C: Higher magnification of the neutrophils showed decreased primary (azurophilic; red arrow) and tertiary (blue) granules. Specific (secondary) granules are not present (x23,000).
A heterozygous variant of unknown significance, c.653T>C (p.Val218AIa), was identified in exon 2 of the CEBPE gene. A second mutation of the CEBPE gene was not detected via gene sequencing, but deletion/duplication analysis was not completed. The presence of large deletions or duplications could not be ruled out. Other deep intronic pathogenic variants as well as variants in other regulatory regions also could not be ruled out.
All of these findings suggest a diagnosis of specific granule deficiency. This patient experienced significant burden of disease from infancy to adulthood. Even after remission of his skin lesions, he remains at elevated risk for severe infections, as demonstrated by mediastinitis, osteomyelitis and bacteremia after surgical or invasive interventions.
This case demonstrates the complex characteristics of primary immunodeficiencies (PID). Patients with PID are at risk of multiple complications, including autoimmune disease, which develops in 20 to 25 percent of patients. These patients require continued monitoring not only for infections but also for granulomatous disease of the lungs, autoimmune disorders, lymphoma, malabsorption and other complications. For these reasons, a team approach is vital to the overall care of our PID patients.
Advertisement
The Adult Immunodeficiency Clinic within Cleveland Clinic’s R.J. Fasenmyer Center for Clinical Immunology works closely with pulmonologists, rheumatologists, hematologists, oncologists and gastroenterologists to provide the best care for these patients. We and our colleagues frequently make decisions about care as a team, and constant communication among physicians is a necessity.
In the end, patients are better served and appreciate a collaborative effort by multiple physicians with specific expertise in managing their primary immunodeficiency and the complications related to it. With a growing number of adult immunodeficiencies being identified, our Adult Immunodeficiency Clinic is fully committed to advancing the care of patients and initiating new research projects in this growing and exciting field.
Dr. Fernandez is staff in the Department of Allergy and Clinical Immunology. Dr. Calabrese leads the R.J. Fasenmyer Center for Clinical Immunology. Dr. Barcena Blanch is a 2016 graduate of our Allergy and Clinical Immunology fellowship.
Advertisement
Advertisement
Volatile organic compounds have potential in heart failure diagnostics
Caregivers are provided with real-time bronchoscopy patient findings
Insights for diagnosing, assessing and treating
A Cleveland Clinic pulmonologist highlights several factors to be aware of when treating patients
New program sets out to better support underserved patient populations
Cleveland Clinic pulmonologists aim to further lower waitlist times and patient mortality
Lessons learned from cohorting patients and standardizing care
New tools and protocols to improve care